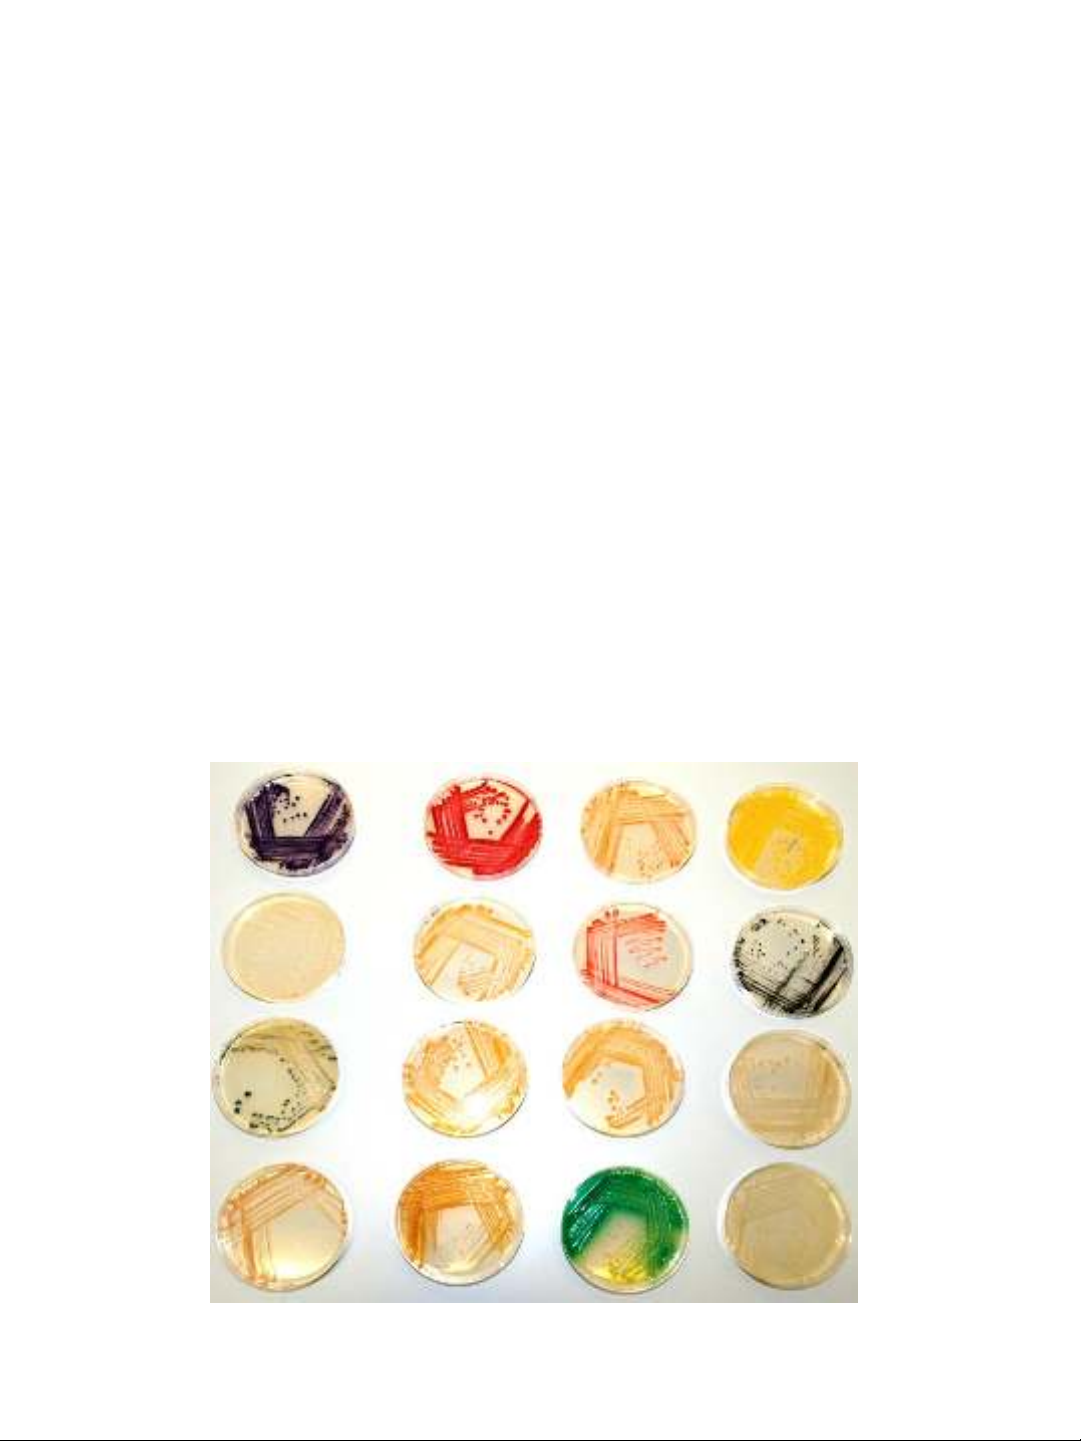

9/18/2020
1
Chương 5. Sinh trưởng của vi sinh vật
•Dinh dưỡng của vi sinh vật
•Nhu cầu dinh dưỡng, thức ăn của vi sinh vật
•Các kiểu dinh dưỡng ở vi sinh vật
•Sinh trưởng của vi sinh vật
•Các phương pháp xác định sự tăng trưởng của vi sinh vật
Có khoảng trên 16 trong số 92 nguyên tố hoá học là thành phần hoá học
của tế bào, chúng được gọi là những nguyên tố sinh học. Trong tế bào và
cơ thể có thể chia các chất thành 2 loại:
Các chất vô cơ như nước, các loại muối, các ion
Những chất hữu cơ như protein, glucid, acid nucleic, lipid, các chất có
hoạt tính sinh học khác
Tế bào còn sống chứa 75-85% nước, 10-20% protein, 2-3% lipid, 1%
glucid, 1% các loại muối và các chất vô cơ khác.
Thành phần hóa học trong tế bào

9/18/2020
2
Nước là môi trường diễn ra các phản ứng chuyển hoá và trao đổi
chất trong tế bào, giữa tế bào và môi trường, điều hoà nồng độ các
chất; là dung môi của phần lớn các chất.
Nước liên kết với protein để tạo nên lớp áo nước rất quan trọng của
các đại phân tử protein
Nước có hoạt tính mạnh khi phân ly thành các ion H+ và OH-, là
nguyên liệu cho các phản ứng sinh hóa
Điều hoà nhiệt độ trong cơ thể và môi trường xung quanh
Nước
Các acid: HCl, H2CO3 phân ly [H+]
Các base: NaOH, NH4OH...phân ly [OH-]
Các muối: NaCl, CaCO3...
Các dung dịch đệm: làm ổn định pH (phosphat, aminoacid, protein)
Vai trò sinh học của các chất vô cơ:
+ Nồng độ các ion hằng định thì tế bào hoạt động bình thường
+ Duy trì áp suất thẩm thấu của các dịch sinh vật
+ Là chất xúc tác trong các phản ứng oxyhoá-khử (Fe, Mn, Zn, Cu...)
+ Duy trì pH của dịch sinh vật (bicacbonat, phosphat, Na, K...)
+ Tham gia thành phần cấu tạo của các hợp chất trong tế bào
Các hợp chất vô cơ khác
9/18/2020
3
•Protein là thành phần quan trọng đặc trưng cho cấu trúc, chức năng của
tế bào.
•Lipid là thành phần quan trọng của màng tế bào.
•Glucid là nguồn năng lượng của tế bào. Tham gia thành phần cấu tạo
màng sinh chất, thành tế bào, bao nhày…
•Acid nucleic là chất có ý nghĩa quan trọng hàng đầu trong sinh học. Hầu
hết các cơ thể sống đều có acid nucleic dưới dạng ADN và ARN
•Vitamin: Rất nhiều coenzyme là vitamin hay dẫn xuất của vitamin. Một
số VSV muốn phát triển bình thường cần cung cấp một hoặc nhiều
vitamin khác nhau.
•Sắc tố: Tham gia vào quang hợp và các hoạt động chức năng khác.
Các hợp chất hữu cơ

9/18/2020
4
Nhu cầu dinh dưỡng của vi sinh vật
•Nhu cầu năng lượng: ánh sáng, hóa học
•Nhu cầu carbon: vô cơ, hữu cơ
•Nhu cầu nitro: N2, NH4+,…
•Nhu cầu axit amin: tự dưỡng, di dưỡng bắt buộc và không bắt buộc
•Nhu cầu khoáng: nguyên tố khoáng đa lượng (P, K, Na, S, Mg,...) và
nguyên tố khoáng vi lượng (Mn, Cu, Co,...).
•Nhu cầu về chất sinh trưởng: Hầu như không có chất nào là chất sinh
trưởng chung cho tất cả các loại vi sinh vật, có thể thuộc về một trong
các loại sau đây: các gốc kiềm purin, pirimidin và các dẫn xuất của
chúng, các acid béo và thành phần của màng tế bào, các vitamine.
Căn cứ vào nhu cầu của vi sinh vật người ta chia thức ăn làm ba
loại:
•Thức ăn năng lượng: thức ăn sau khi hấp thụ cung cấp một số năng
lượng cần thiết cho hoạt động sống của vi sinh vật như gluxit,
lipit…
•Thức ăn kiến tạo: thức ăn sẽ chuyển hóa tham gia xây dựng các cấu
trúc của vi sinh vật. Trong thực tế một loại thức ăn vừa có thể là
nguồn năng lượng, vừa là nguyên liệu để xây dựng cấu trúc như
protein…
•Yếu tố sinh trưởng (thức ăn đặc hiệu): là những chất cần thiết đối
với hoạt động sống, mà vi sinh vật không tự tổng hợp được như
vitamin, axit amin không thay thế như Tryptophan…
Thức ăn của vi sinh vật

9/18/2020
5
Căn cứ vào nguồn carbon
•Dị dưỡng carbon: vi sinh vật sử dụng nguồn carbon trong tự nhiên từ các
hợp chất hữu cơ. Từ hợp chất hữu cơ này ngoài nguồn carbon vi sinh vật còn
thu được nguồn năng lượng cần thiết cho hoạt động sống của mình.
•Tự dưỡng carbon: là nhóm vi sinh vật sử dụng nguồn các bon từ các chất
vô cơ như CO2 hoặc các muối carbonate. Quá trình này cần năng lượng, vi
sinh vật có thể sử dụng nguồn năng lượng trực tiếp của ánh sáng mặt trời
hoặc sử dụng năng lượng hóa học nhờ sự oxi hóa hợp chất vô cơ.
Căn cứ vào nguồn năng lượng
•Dinh dưỡng quang năng: là những vi sinh vật nhờ có sắc tố quang hợp mà
có khả năng hấp thu năng lượng từ ánh sáng mặt trời và chuyển hóa thành
năng lượng hóa học (tích lũy dưới dạng ATP)
•Dinh dưỡng hóa năng: là những vi sinh vật sử dụng năng lượng chứa trong
các hợp chất hóa học.
Các kiểu dinh dưỡng ở vi sinh vật
Căn cứ vào nguồn carbon và nguồn năng lượng
Tự dưỡng
•Tự dưỡng quang năng: Nguồn C là CO2, nguồn năng lượng là ánh sáng.
•Tự dưỡng hoá năng: Nguồn C là CO2, nguồn năng lượng là một số hợp chất
vô cơ đơn giản.
Dị dưỡng: Vi sinh vật đòi hỏi một phần hoặc toàn bộ nguồn dinh dưỡng phải là
chất hữu cơ có sẵn như hydrate carbon (đường, tinh bột, cellulose ,...). Còn
nguồn N là các acid amine, yếu tố phát triển hoặc sinh trưởng là các vitamine,
hoặc các chất chuyển hóa.
•Dị dưỡng quang năng: Nguồn C là chất hữu cơ, nguồn năng lượng là ánh
sáng.
•Dị dưỡng hoá năng: Nguồn C là chất hữu cơ, nguồn năng lượng là từ sự
chuyển hoá trao đổi chất của chất nguyên sinh của một cơ thể khác.
•Dị dưỡng hoại sinh: Nguồn C là chất hữu cơ, nguồn năng lượng là từ sự trao
đổi chất của chất nguyên sinh các xác hữu cơ.
•Dị dưỡng kí sinh: Nguồn C là chất hữu cơ, nguồn năng lượng là lấy từ các tổ
chức hoặc dịch thể của một cơ thể sống.

